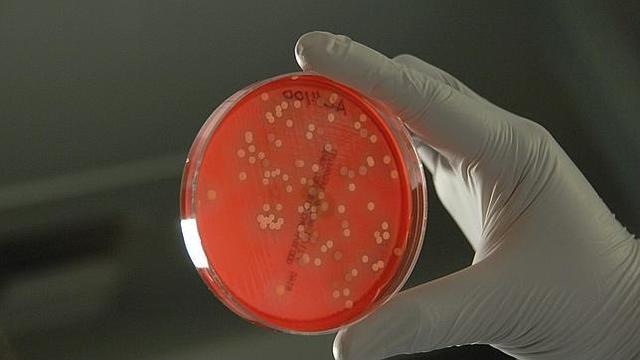
¿Cuándo surgió el primer cerebro y en qué organismo?

-
Empezó a constituirse con Hipocrátes en el siglo v a. C. Y hoy en día es de conocimiento saber que todos los animales la poseen desde hace millones de años. Los poriferos y esponjas marinas aportaron bases genéticas para la constitución de neuronas y sinapsis.
-
Las bacterias son capaces de percibir, recordar y desplazarse. Algunas bacterias coliformes, como la Escherichia Coli habitan en nuestro tracto intestinal y poseen en su superficie más de una docena de receptores con diferentes funciones pseudocerebrales: memoria, toma de decisiones o control de la conducta.
-
Los primeros seres con registro de neuronas y sistema nervioso fueron las medusas y las hidras, contaban con una red de neuronas bipolares y multipolares que captaban informacion de forma química, mecánica y lumínica.
-
La agrupación mas primitiva es la de los gusanos planos. pero da algunas trazas de especialización, ya que las neuronas se concentran en tres o cuatro pares de cordones longitudinales, manejan un cerebro por acumulación de neuronas.
-
El zoologo Anton Dohrn notó las similitudes anatómicas entre los nervios que están a lo largo de los cuerpos de los anélidos, que es un grupo de gusanos invertebrados. Propuso la existencia de un grupo de animales primigenio que debía tener un cordón nervioso que correría a lo largo de sus cuerpos en el lado ventral. Luego, más tarde, en animales más recientes, este cordón emigró hacia la parte opuesta, es decir, la espalda, para dar lugar a los vertebrados.
-
Actualmente son conocidos las siguientes organizaciones nerviosas. Los anillos nerviosos, Estos anillos se forman debido a una tensión excesiva prolongada en el organismo que se refleja en las fibras del iris. Cordones nerviosos se encuentran en todos los animales del filo cordados tienen un cordón nervioso dorsal, y en los vertebrados, este órgano se corresponde con la médula espinal.
-
Los ganglios son agrupaciones de los cuerpos de las neuronas. Están rodeadas por una cápsula de tejido conectivo y los axones (o prolongaciones neuronales) que parten de los ganglios forman parte de los nervios. A lo largo de la evolución de los mamíferos, desde hace mas de 60 millones de años, el desarrollo del cerebro se considera una primera y verdadera revolución en comparación al proceso conservador que había mantenido este desarrollo hasta entonces. Según Jerison (1973):
-
Probablemente las neuronas aparecieron por primera vez en Cnidarios hace unos 700 millones de años. Esto, junto con la presión selectiva pudo inducir en varias ocasiones la especialización de tejido epitelial para la transducción de la información y actuar como células sensoriales, como interneuronas (integración o transmisión del impulso nervioso). Desde los hidrozoos hasta los anfibios, pasando por ctenóforos, tunicados o moluscos.
-
El cerebro humano sería el resultado de la evolución de millones de años a partir de la estructura cerebral de los reptiles, ya que la parte más primitiva del cerebro del homo sapiens es el cerebro reptiliano, que está conectado con la parte superior de la médula espinal. En el cerebro, en términos generales, reside nuestra mente, la inteligencia, los sentimientos, la memoria, la espiritualidad y la consciencia de lo que hemos sido, somos y posiblemente seremos.
-
Investigadores de la universidad de Arizona encontraron el china un fósil de un artrópodo de hace 520 millones de años, donde se nota claramente un cerebro bien conservado y donde afirman que ha sido poco el cambio en cuanto a su evolución.
-
El proceso de evolución y humanización del cerebro del Homo sapiens lo convirtió en un órgano único y diferente, alcanzando un mayor tamaño relativo entre todas las especies, pero además le permitió una reorganización estructural de tejidos y circuitos en segmentos y regiones específicas. Esto explica las notables capacidades cognitivas del hombre moderno, en comparación no solo con otros miembros de su género, sino con otros miembros más antiguos de su propia especie.
-
Se Origino en África alrededor de seis millones de años, evoluciono de tal manera que podían mantenerse erguidos y desplazarse de forma bípeda. Características de los homínidos es el progresivo aumento del volumen cerebral, siendo mayor que el de otros simios en relación a su envergadura. Este desarrollo ha permitido mayor desarrollo cognitivo y la aparición de una capacidad de socialización e intelecto cada vez más notorios, permitido fabricar y utilizar herramientas o crear arte.